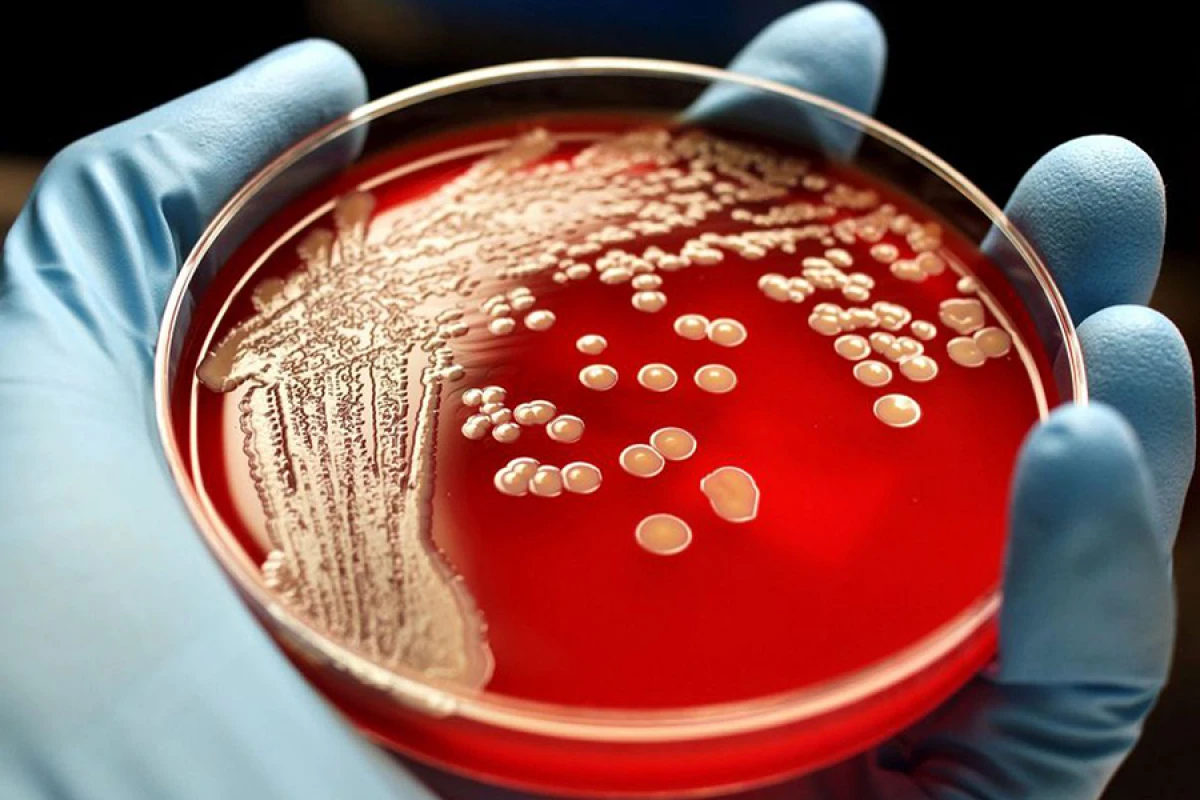

0
7
Карантинні правила для навчальних закладів. Інфографіка
13-08-2020, 03:00
До початку навчального року залишилося лише декілька тижнів. Усі школярі, крім районів “червоної зони” за рівнем поширення Covid-19, підуть до школи.